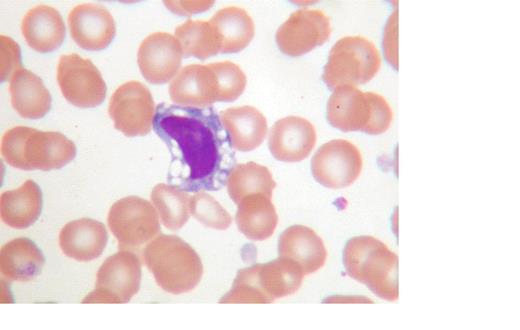
graphic

Pyknotic lymphocytes were infrequently observed in routine blood film evaluation of patients with clinical infectious mononucleosis. A marked increase in frequency was observed in 1995-1997.
To characterize the cause of these changes.
Collection of samples from patients (25) with clinical infectious mononucleosis to ascertain the effect of anticoagulant and/or time lapse on lymphocytes and to correlate with monospot or Epstein-Barr virus antibody testing. Control samples (33), mixed hematopoietic disease (29) and lymphoproliferative disorders (36) were obtained also. Additional patients (53), identified by variant lymphocyte morphology during routine CBC’s, were verified by monospot or EBV testing and slides were made at 24 and 48 hours for differentials. Finally, single specimens (86) were obtained to establish predictability or correlation between pyknotic cells and monospot testing
| Infectious Mononucleosis . | |
|---|---|
| Study Population . | . |
| Patients | 25 |
| Controls | 33 |
| “Other” Disease | 29 |
| Lymphoproliferative Disease | 35 |
| Patient (EDTA only) | 53 |
| Single Specimens | 86 |
| Total | 267 |
| Infectious Mononucleosis . | |
|---|---|
| Study Population . | . |
| Patients | 25 |
| Controls | 33 |
| “Other” Disease | 29 |
| Lymphoproliferative Disease | 35 |
| Patient (EDTA only) | 53 |
| Single Specimens | 86 |
| Total | 267 |
Inpatient and outpatient hematology laboratory.
Patients with clinical infectious mononucleosis demonstrated 8-10% pyknotic lymphocytes in 24 and 48 hour samples in all three anticoagulants (see Figure 1) compared with controls, “other diseases” (Table 2) and lymphoproliferative disorders (Table 3). An unexpected predictive correlation of pyknotic cells with positive monospot or Epstein-Barr Virus antibodies was demonstrated when pyknotic cells were seen with or without significant atypical lymphocytes during daily routine differential counting.
| “Other” Diseases (Mixed) . | |
|---|---|
| Hepatitis . | 6 . |
| Viral infection-rotovirus, RSV, ?other | 5 |
| No Disease | 5 |
| URI | 4 |
| Chicken Pox | 2 |
| Iron deficiency/thalassemia | 2/1 |
| Pertussis | 2 |
| Diabetes | 1 |
| ITP | 1 |
| Lead Exposure | 1 |
| “Other” Diseases (Mixed) . | |
|---|---|
| Hepatitis . | 6 . |
| Viral infection-rotovirus, RSV, ?other | 5 |
| No Disease | 5 |
| URI | 4 |
| Chicken Pox | 2 |
| Iron deficiency/thalassemia | 2/1 |
| Pertussis | 2 |
| Diabetes | 1 |
| ITP | 1 |
| Lead Exposure | 1 |
| Lymphoproliferative (LPD) . | |
|---|---|
| Chronic Lymphocytic Leukemia . | 21 . |
| Lymphocytic Lymphoma | 5 |
| Acute Lymphoblastic Leukemia | 2 |
| Sezary Cell Leukemia | 2 |
| Mantel Cell Leukemia | 1 |
| Hairy Cell Leukemia | 1 |
| LGL Leukemia | 1 |
| Pseudolymphoma | 1 |
| Pseudolymphoma | 1 |
| Lymphocytosis, etiology? | 1 |
| Lymphoproliferative (LPD) . | |
|---|---|
| Chronic Lymphocytic Leukemia . | 21 . |
| Lymphocytic Lymphoma | 5 |
| Acute Lymphoblastic Leukemia | 2 |
| Sezary Cell Leukemia | 2 |
| Mantel Cell Leukemia | 1 |
| Hairy Cell Leukemia | 1 |
| LGL Leukemia | 1 |
| Pseudolymphoma | 1 |
| Pseudolymphoma | 1 |
| Lymphocytosis, etiology? | 1 |
Observation of pyknotic lymphocytes adds a significant and inexpensive element to the diagnosis of infectious mononucleosis and consideration of Cytomegalic Virus infection in older patient
No relevant conflicts of interest to declare.
Author notes
Asterisk with author names denotes non-ASH members.

This feature is available to Subscribers Only
Sign In or Create an Account Close Modal